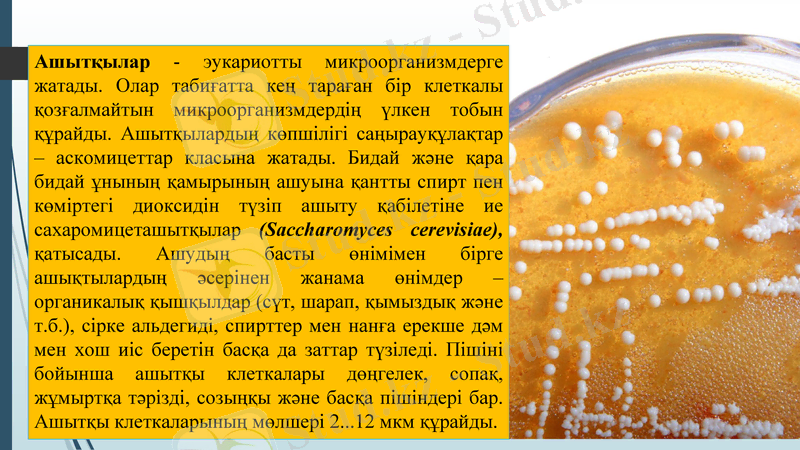
Slide 2

Ашытқылар мен микромицеттер: морфологиясы, көбеюі және биотехнологиялық өнеркәсіпте қолданылуы



Ашытқылар мен микромицеттер биотехнологиялық өнеркәсіптің негізгі нысандары
Қазақстан Республикасы Білім және Ғылым министірлігі
Әл-Фараби атындағы Қазақ Ұлттық Университеті
Биология және биотехнология факультеті
Ашытқылар - эукариотты микроорганизмдерге жатады. Олар табиғатта кең тараған бір клеткалы қозғалмайтын микроорганизмдердің үлкен тобын құрайды. Ашытқылардың көпшілігі саңырауқұлақтар - аскомицеттар класына жатады. Бидай және қара бидай ұнының қамырының ашуына қантты спирт пен көміртегі диоксидін түзіп ашыту қабілетіне ие сахаромицеташытқылар (Saccharomyces cerevisiae), қатысады. Ашудың басты өнімімен бірге ашықтылардың әсерінен жанама өнімдер - органикалық қышқылдар (сүт, шарап, қымыздық және т. б. ), сірке альдегиді, спирттер мен нанға ерекше дәм мен хош иіс беретін басқа да заттар түзіледі. Пішіні бойынша ашытқы клеткалары дөңгелек, сопақ, жұмыртқа тәрізді, созыңқы және басқа пішіндері бар. Ашытқы клеткаларының мөлшері 2 . . . 12 мкм құрайды.

Ашытқы клеткаларының құрылымы. Ашытқы клеткалары сыртқы ортадан клетка қабығымен 1 бөлінген. Ол клетканы лайсыз әсерден қорғайды және оның пішінін анықтайды. Клетка қабығының астында зат алмасуда үлкен қызмет атқаратын цитоплазмалық мембрана 8 бар. Клетка цитоплазмамен 4 толтырылған, онда нуклеоид 2, гликоген дәндері 3, метахроматин 5, вакуолдер6, митохондриялар 7, рибосомалар 9 орналасқан.

Ашытқылардың арасында сапрофиттер мен паразиттер болады. Сапрофиттер ашыту өнеркәсібінде және ақуыз көзі ретінде мал шаруашылығында пайдаланылады. Бластомикоз паразиттері малдардың ауруын қоздырады. Ашытқы қалталы саңырауқұлақтар (Ascomycetes) класының мицелий түзбейтін жалаңаш қалталы кіші тобына жатады. Ең үлкен қызығушылықты оятатын сахаромицес (Saccharomyces) тегі. Оның құрамына өнеркәсіпте қолданылатын ашытқының табиғи және өсірілген түрлері жатады. Олардың жеке түрлерімен қантты ашытады.
Ц е р е в и з и я с а х а р о м и ц е с і ашытқысы кеңінен қолданылады. Түрлі әдіспен пресстелген және кептірілген ашытқы коммерциялық өнім болып табылады. Тағам ашықтылары азық-түлік өнімдеріне қосымша зат түрінде пайдаланылады. Ашытқыны өндірісте инвертаза ферментін, этил спиртін өндіруде, квас қайнатуда, нан пісіруде және сыра қайнатуда қолданады. Әрбір үдеріс үшін ашытқының өз түрі қажет.


Ашытқылар екі жолмен көбейеді: жыныссыз, немесе вегетативті (бүршіктену), және жынысты (спора түзу) . Вегетативті көбею келесідей жүреді. Бірінші бастапқы (аналық) клеткада кіші-гірім төбешік - бүршік пайда болады, ол өскен сайын мөлшері ұлғаяды. Сонымен бір уақытта нуклеоидтың екі бөлікке бөлінуі жүреді. Цитоплазманың бөлігі және клетканың басқа элементтерімен нуклеоидтың бірі жас (еншілес) клеткаға өтеді. Жас клетканың өсуімен оның аналық клеткамен байланыстырып тұрған тарту жіңішкереді, солайша еншілес клетка ажырап, кейін бөлініп, аналық клеткадан алшақтайды. Бүршіктені процесі бірнеше сағат жүреді. Бір аналық клетка 8 . . . 10 клеткаға бүршіктенуі мүмкін. Әр қайта түзілген клетка өз кезегінде солайша бүршіктеніп бастайды. Бұл процесс қолайлы жағдайда ғана жүреді. Қолайсыз жағдайда кейбір ашытқылар жыныссыз, яғни клеткалардың қосылуынсызспоралар түзеді.
КӨБЕЮІ


Қазіргі таңда этанол өндірісінде ең көп қолданылатын микроорганизм Saccharomyces cerevisiae ашытқысы болып табылады. S. cerevisiae ашытқысын, сондай-ақ «наубайхананың ашытқысы» деп те атайды, гексозды қанттардан этанолды дайындау тарихқа дейінгі дәуірлерде қалыптасқан. Лигноцеллюлозадан этанол өндіру үшін
бірнеше микроорганизмдер қарастырылды, оның ішінде бактериялар да, ашытқы да бар. S. Cerevisiae ашытқылары гидролизат құрамындағы соңғы өнім этанолға және басқа да қосылыстарға толеранттылығы нәтижесінде бактерияларға қарағанда тұрақтылық көрсетеді. Сонымен қатар, S. Cerevisiae ашытқысы «Қауіпсіз» (GRAS, қауіпсіз деп танылған) ағзалар тізіміне енгізілген. Алайда табиғи ашытқы S. cerevisiae құрамында 1, 4-β-гликозил- гидролаза (целлюлаза) гендері болмайды, сондықтан олар өсімдік жасушаларының қабырғаларында орналасқан целлюлозаны ашытуға қабілеттілігі жоқ. Бірақ глюкозаны этанолға дейін ашытудың жоғарғы көрсеткіші мен ортада этанолдың жоғары құрамына төзімділігі үшін S. cerevisiae ашытқысы целлюлоза бар биомассаны биоотынға айналдыруға ең қолайлы кандидат болып табылады. Сонғы жылдары гендік инженерия саласында барлық күш жігер целлюлозаны ашытуға қабілетті ашытқыларды құрастыруға жұмсалуда, атап айтқанда S. сerevisiae клеткасында целлюлазаны кодтайтын гендерді клондауға назар аударылуда.
Өндірістегі маңыздылығы

Saccharomyces cerevisiae қолданылатын өндірістер

Саңырауқұлақтар табиғатта кеңінен тараған. Олар жеке патшалыққа бөлінген организмдердің үлкен тобын құрайды. Саңырауқұлақтар патшалығына микроскопиялық мицелиалды саңырауқұлақтар (ертерек олардың зең саңырауқұлақтары деп атаған) да кіреді. Микроскопиялық мицелиалды саңырауқұлақтардың өкілдері Aspergillus (аспергиллус), Penicillium (пенициллиум), Mucor (мукор), Fusarium (фузариум) туыстары және әр түрлі класқа жататын басқа да саңырауқұлақтар болып табылады. Олар ашыту қамыры мен қамырда кездеседі.
Құрылымы. Микроскопиялық мицелиалды саңырауқұлақтардың клеткалары созылған пішінге ие және гифтер деп аталады. Бір-бірімен өріліп, жіп тәрізді гифтер саңырауқұлақ денесін түзеді. Олар мицелии немесе саңырауқұлақ жіпшесі деп аталады. Мицелиий мақта, мамық нәрсеге ұқсас немесе басқа түзіліске тартқан.

Мукор
Мукор - оларды сақтау жағдайларын бұза отырып, тамақ өнімдері, топырақ, өсімдіктердің органикалық заттарынан туындайтын көгерудің саңырауқұлағы. Алғашқы кезеңде бұл ақшыл көгалдарға ұқсайды, сондықтан оның есімі ақ көгерген. Колониялар өтіп бара жатқанда, спорангияның қалыптасуы саңырауқұлақтарды одан әрі шығара бастайды. Олар мукорды сұр немесе бежевый түс береді, ал пісіп-жетілдіру уақыты толықтай қара.

Мукор құрылысы
Микроскоптың астында мукор колониясы өте қызықты көрінеді. Оның негізі - көптеген ядролары бар үлкен тармақталған жасуша болып табылатын мицелия.
Ақ жіптердің (гифа) көмегімен бұл орган топырақта бекітілген. Нағыз тамырлар секілді, бұл жіптер филиалы мицелияның шеттеріне жақындай түсуде.
Ашық көзге көрінетін қалып - бұл спортангиофорлар, негізгі мицелиядан өсетін шаштар.
Егер паразит ыңғайлы жағдайда тұрса, онда бұл шаштар биіктігі бірнеше сантиметрге жетеді. Микроорганизмдердегі бактериялардың жетілу процесінде репродуктивті споралар бар спорангия - қораптар пайда болады.
Егер дамудың осы сатысында микроскоп астында саңырауқұлаққа қарасаңыз, онда оның сыртқы түрі жасырын тәріздес жастыққа ұқсайды. Сондықтан, бұл саңырауқұлақтар көбінесе капидаттың пішіні деп аталады.
- Іс жүргізу
- Автоматтандыру, Техника
- Алғашқы әскери дайындық
- Астрономия
- Ауыл шаруашылығы
- Банк ісі
- Бизнесті бағалау
- Биология
- Бухгалтерлік іс
- Валеология
- Ветеринария
- География
- Геология, Геофизика, Геодезия
- Дін
- Ет, сүт, шарап өнімдері
- Жалпы тарих
- Жер кадастрі, Жылжымайтын мүлік
- Журналистика
- Информатика
- Кеден ісі
- Маркетинг
- Математика, Геометрия
- Медицина
- Мемлекеттік басқару
- Менеджмент
- Мұнай, Газ
- Мұрағат ісі
- Мәдениеттану
- ОБЖ (Основы безопасности жизнедеятельности)
- Педагогика
- Полиграфия
- Психология
- Салық
- Саясаттану
- Сақтандыру
- Сертификаттау, стандарттау
- Социология, Демография
- Спорт
- Статистика
- Тілтану, Филология
- Тарихи тұлғалар
- Тау-кен ісі
- Транспорт
- Туризм
- Физика
- Философия
- Халықаралық қатынастар
- Химия
- Экология, Қоршаған ортаны қорғау
- Экономика
- Экономикалық география
- Электротехника
- Қазақстан тарихы
- Қаржы
- Құрылыс
- Құқық, Криминалистика
- Әдебиет
- Өнер, музыка
- Өнеркәсіп, Өндіріс
Қазақ тілінде жазылған рефераттар, курстық жұмыстар, дипломдық жұмыстар бойынша біздің қор #1 болып табылады.



Ақпарат
Қосымша
Email: info@stud.kz